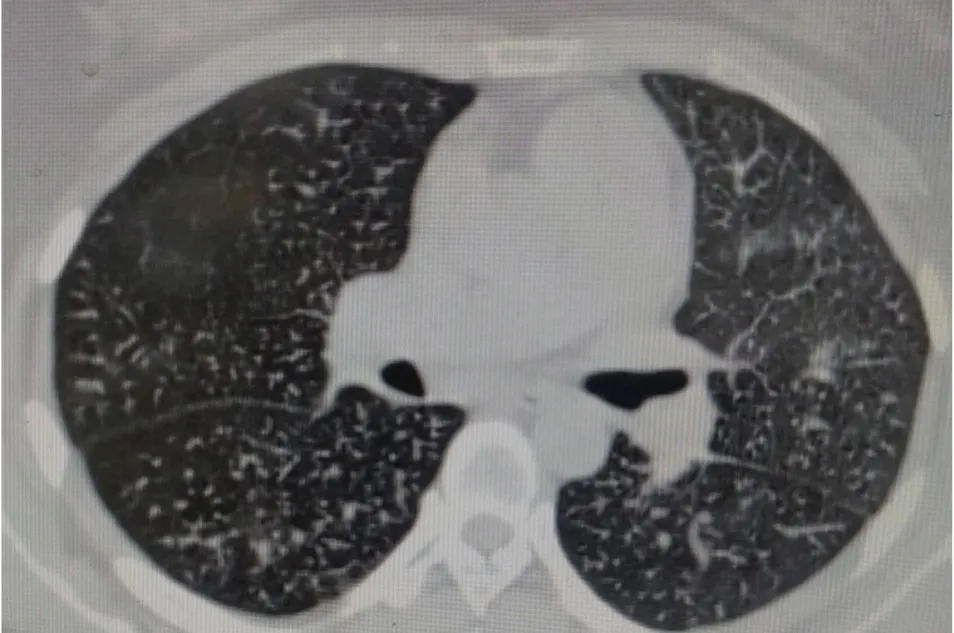
1738660798665005081.png

您好,欢迎访问陕西省中医药研究院陕西省中医医院官方网站!
近日,陕西省中医医院肺病科与病理科协作确诊一例特发性肺含铁血黄素沉着症患者。程某,女性,33岁,2025年1月8日以“反复咳嗽,咳痰,气短1年余,加重2月”为主诉入院。
患者自2024年4月无明显诱因出现阵发性咳嗽,咳少量白色泡沫痰,间断痰中带血,活动后气短。在当地县医院诊断为“支气管哮喘”,对症治疗后症状略有减轻。此后,上述症状反复发作,并呈进行性加重。曾先后在西安某某大学第一附属医院及某某医院就诊,行肺功能检查示“中重度混合性肺通气功能障碍”,CT示“双肺纹理紊乱,考虑支气管炎”,气管镜下无明显异常,按“慢阻肺”治疗无效。2024年11月,患者自觉咳嗽,气短较前加重,稍事活动后即气短乏力,咯血量较前增多,在当地县医院治疗无效后前来我院门诊以“慢性阻塞性肺病”收住入院。
入院后,主管医生孙昉昉副主任医师尽快完善相关检查,血气分析提示氧分压62mmHg(正常人>80mmHg)。1月9日我院CT示:弥漫性粟粒样肺结节,以双下肺为主,伴有间质性炎症改变,肺动脉高压。心脏超声示:肺动脉高压,肺源性心脏病,少量心包积液。肺功能示:重度混合型肺通气功能障碍。
由于患者病情复杂,马战平主任组织科室进行疑难病例讨论。患者病情特点:一是病史1年余,主要表现为反复咳嗽,咳痰,气短,病情呈进展性,伴有痰中带血;二是有低氧血症,肺源性心脏病;三是肺功能示重度混合性肺通气功能障碍;四是影像学提示弥漫性粟粒状结节影,以中下肺为主,部分融合成纤维化,肺动脉高压。讨论结果考虑肺结节病或肺含铁血黄素沉着症可能性大,需要做气管镜以明确诊断。

1月10日,谭国超副主任医师给患者行电子支气管镜检查,并取了活检。
1月14日病理结果提示:(右肺下叶活检组织标本)慢性支气管炎,局部可见含铁血黄素沉积。

这是肺病科确诊的第二例特发性肺含铁血黄素沉着症。随着高端呼吸介入设备和高水平人才的引进,科室对呼吸系统罕见疾病诊治水平在不断提高。
什么是特发性肺含铁血黄素沉着症?
特发性肺含铁血黄素沉着症是一种罕见的,发病原因不明的疾病,可能与遗传、环境、免疫、过敏等有关。临床以弥散性肺泡出血和继发性缺铁性贫血为特征,大量的含铁血黄素沉着于肺泡内,最终可发生肺间质纤维化。主要临床表现为发作性、进展性,反复咳嗽、咳痰、咯血、呼吸困难、乏力、消瘦;CT表现为双肺弥漫性斑片影,以双下肺为主;肺活检可见含铁血黄素颗粒。临床表现与肺出血程度密切相关。典型的三联征是反复咯血、缺铁性贫血、胸部影像呈弥漫性肺部浸润。该病的治疗以糖皮质激素、免疫抑制剂为主。病情预后因人而异,尽早控制急性发作、减少急性发作次数是改善预后的关键。
备案号:陕ICP备17003884号-1
电话:029-87213310 【全年咨询时间】08:00-12:00;14:00-17:30
Copyright © 版权所有:All Rights Reserved 陕西省中医医院
陕西省中医医院
陕西省中医药研究院